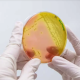
Agrosavia reafirma su compromiso con la bioeconomía: busca aprovechar el potencial de los microorganismos en la agricultura sostenible

Agrosavia reafirma su compromiso con la bioeconomía: busca aprovechar el potencial de los microorganismos en la agricultura sostenible
Colombia cuenta con una de las mayores diversidades microbianas del mundo. Para aprovechar este patrimonio biológico, la entidad desarrolló un plan que articula capacidades científicas, institucionales y territoriales, orientado a generar tecnologías, productos y servicios de valor agregado que propenden por la democratización del conocimiento.
Agrosavia buscar posicionar a Colombia como referente en bioprospección microbiana mediante conocimiento científico, innovación y uso sostenible de la biodiversidad. Por ello, la entidad diseñó el Plan Estratégico de Bioprospección de Microorganismos, una hoja de ruta que orienta las actividades de investigación, desarrollo e innovación (I+D+i) en torno al uso sostenible de los recursos microbianos de la agrobiodiversidad del país.
De acuerdo con la entidad, este instrumento, basado en las capacidades corporativas y las tendencias globales en línea con las políticas públicas nacionales, propone cuatro objetivos, nueve estrategias y más de 30 líneas de acción que promueven la transformación del sector agropecuario a través del conocimiento científico, la tecnología y la bioeconomía.
“Con esta iniciativa, Agrosavia reafirma su compromiso con la bioeconomía, la sostenibilidad ambiental y la transformación del campo colombiano, posicionando la bioprospección microbiana como un eje estratégico para enfrentar desafíos globales como el cambio climático, la seguridad alimentaria y la resistencia antimicrobiana”, dijo Ivette Marcela Cabrales Campo, investigadora del grupo de Bioprospección de la entidad.
COLOMBIA CUENTA CON UNA DE LAS MAYORES DIVERSIDADES MICROBIANAS DEL MUNDO
Colombia cuenta con una de las mayores diversidades microbianas del mundo. Para aprovechar este patrimonio biológico, Agrosavia desarrolló un plan que articula capacidades científicas, institucionales y territoriales, orientado a generar tecnologías, productos y servicios de valor agregado que propenden por la democratización del conocimiento.
El plan se enfoca en el Banco de Germoplasma de Microorganismos para la Alimentación y la Agricultura (BGAA) administrado por la entidad, así como en otros recursos microbianos no explorados o que ya han sido reconocidos por su potencial diversificación de usos y aplicaciones.
El plan propone líneas de acción clave como:
Fortalecer la investigación en bioprospección mediante enfoques transdisciplinarios y colaboraciones intra e interinstitucionales de carácter nacional e internacional.
Desarrollar capacidades tecnológicas en edición génica, tecnologías ómicas, bioinformática y uso de grandes volúmenes de datos.
Impulsar alianzas estratégicas con actores de la cuádruple hélice (sector público, privado, academia y sociedad civil) para escalar tecnologías y consolidar modelos bioeconómicos.
-Fortalecer las capacidades institucionales de negociación para la conformación de alianzas que permitan el desarrollo de procesos I+D+i, transferencia tecnológica y emprendimientos de base biotecnológica.
Fomentar la apropiación social del conocimiento, mediante estrategias de comunicación científica y participación en la construcción de políticas públicas.
El plan también prioriza el desarrollo de capacidades en territorios mediante investigación participativa, promoviendo la interacción entre comunidades, productores, extensionistas e investigadores para resolver problemáticas locales con soluciones basadas en microbiología aplicada.







